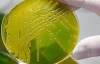
Смертоносну бактерію E.сoli випустили терористи?

Кількість загиблих від кишкової інфекції у Німеччині зросла до 35 людей. Про це повідомляє в ніч на понеділок німецьке видання ZEIT.
Згідно з основною версією вчених, джерелом зараження є пророщені злаки.
Спалах кишкової інфекції вперше був зафіксований на півночі Німеччини. Спочатку передбачалося, що переносником небезпечних бактерій є салатні огірки з Іспанії, але це припущення не підтвердилося. Потім фахівці заявили, що джерелом інфекції могла стати ферма в Нижній Саксонії, яка поставляє на ринки країни пророщену сою та інші злаки, які використовують для приготування салатів і других страв.
Інфекцію викликала ентерогеморагічна бактерія Escherichia coli (кишкова паличка). Бактерія E.coli часто присутня в кишечнику людей і теплокровних тварин. Більшість її штамів нешкідливі, але деякі штами, такі, як ентерогеморагічна кишкова паличка (EHEC), можуть викликати важкі хвороби харчового походження.
Симптоми викликаються бактеріями EHEC хвороб - кривава діарея, жар і блювота. Більшість пацієнтів одужує протягом десяти днів, але у незначної кількості пацієнтів (дітей раннього віку та людей похилого віку) хвороба може прийняти важку форму з загрозою для життя.
Раніше повідомлялося, смертоносна бактерія E.coli підбирається до України.

Коментарі
1